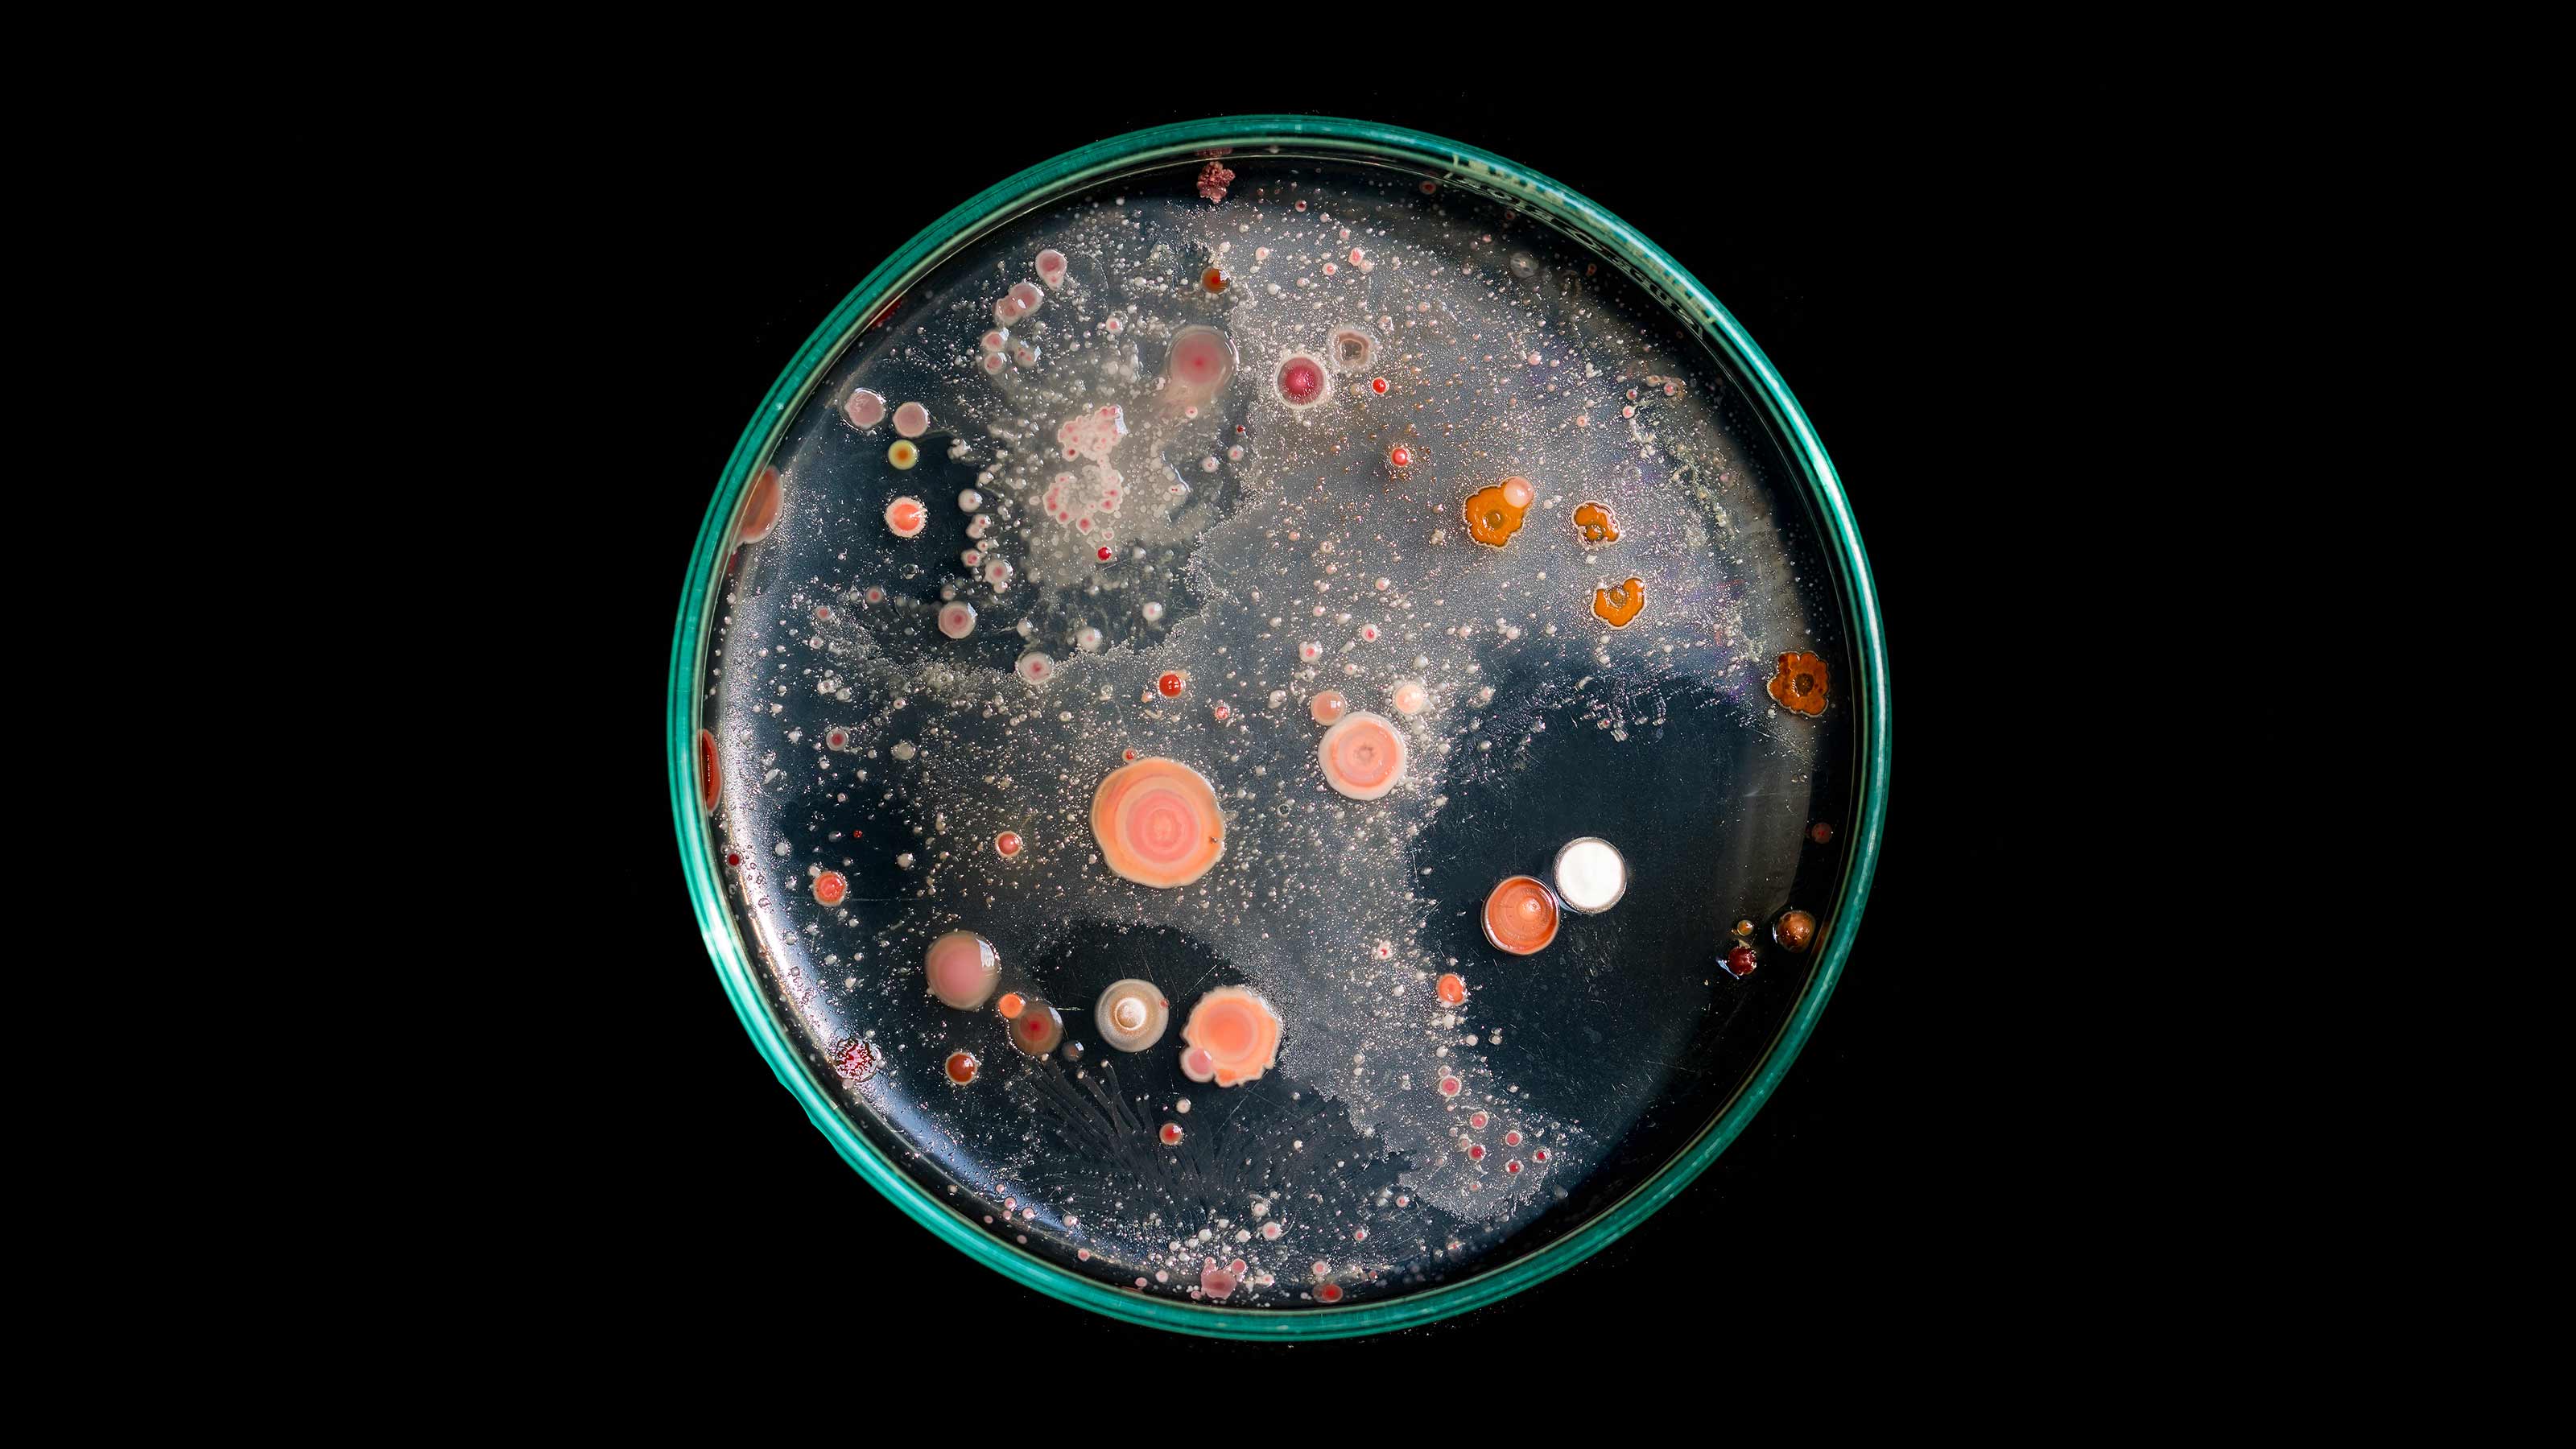
human challenge trial

Biohacking
Wearable health monitors help predict flu before symptoms start
A human challenge trial suggests that wearable health monitors could help predict flu and cold infections before symptoms appear.
This implanted microchip may one day control your sleep
An implantable, wireless device could be better than popping a pill.
What it’s like to do a human challenge trial
Human challenge trials are risky, but they could help us avoid another prolonged pandemic.
Smartphones can track your blood sugar levels
The ability to easily monitor blood sugar levels would allow everyone to have more control over their own metabolic health — not just people with diabetes.
Gifts for the biohacker in your life
This year has put health front of mind for many of us. Biohackers are all about knowing themselves, and with this gift guide, you’ll look like you know them.
Elon Musk: Neuralink brain implant detects pigs' movements
During a livestream, CEO Elon Musk presented the latest Neuralink brain implant, as well as what he claimed were several pig recipients of the device.
How to radically biohack your mind
Brain-computer interfaces could enable humans to "merge with AI."
Fecal transplant cures man whose gut made him drunk
A fecal transplant cured a man of auto-brewery syndrome, a rare condition in which the gut converts carbs into alcohol, making a person feel drunk.
Hack your dreams to improve your waking life
These scientists want to hack your dreams to improve your creativity and memory.
Series|
Biohackers
DIY biohacking: Do(n’t) try this at home
Dr. Josiah Zayner believes scientists are dragging their feet on realizing CRISPR’s potential, so his do-it-yourself CRISPR kit allows people to experiment with gene editing at home.